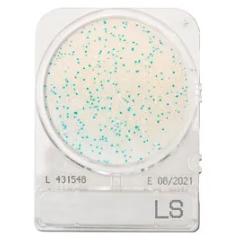
CompactDry™ LS for Listeria species
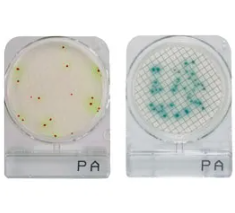
CompactDry™ PA for Pseudomonas aeruginosa
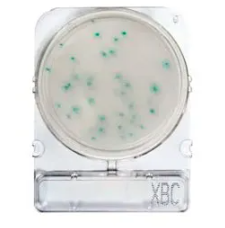
Compact Dry® X-BC (Bacillus cereus)
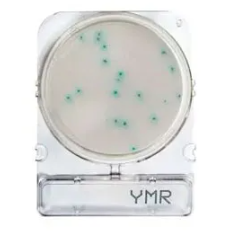
Compact Dry® YMR rapid (moulds and yeasts)

The Lab
Sourcing Group
Sourcing Group
-
Vegyszerek
-
-
Mikrobiológiai termékek
-
-
Szűréstechnika
-
-
Laboratóriumi eszközök
-
Üvegáru
Főzőpoharak, lombikok, tálak Laboratóriumi üvegek Mérőeszközök (mérőlombikok, mérőhengerek, pipetták, büretták, adagolók) Szűréstechnikai eszközök Tölcsérek, csepegtető és választó tölcsérek Hűtők és egyéb csiszolatos eszközök Üvegtechnikai eszközök Küvetták Exszikátorok és mérlegedények Hőmérők, areométerek, fokolók, piknométerek Fecskendők Kémcsövek, egyéb csövek Egyéb üvegáruMűanyag eszközök
Tárolóedények Mérőeszközök Főzőpoharak, lombikok, edények Spriccflakonok, cseppentőflakonok, permetezők Csövek, tesztcsövek Pipettahegyek Állványok, tárolódobozok, tálcák Teflonszerű műanyagból készült termékek Sejttenyésztéshez és mikrobiológiához használt eszközök Kanalak, spatulák, csipeszek Tölcsérek Egyéb műanyag eszközök
-
-
Készülékek, műszerek
-
- Kromatográfiás termékek
- Védőfelszerelések
-
Gyorstesztek
-


 Kosár0
Kosár0
-
Vegyszerek
-
-
Mikrobiológiai termékek
-
-
Szűréstechnika
-
-
Laboratóriumi eszközök
-
Üvegáru
Főzőpoharak, lombikok, tálak Laboratóriumi üvegek Mérőeszközök (mérőlombikok, mérőhengerek, pipetták, büretták, adagolók) Szűréstechnikai eszközök Tölcsérek, csepegtető és választó tölcsérek Hűtők és egyéb csiszolatos eszközök Üvegtechnikai eszközök Küvetták Exszikátorok és mérlegedények Hőmérők, areométerek, fokolók, piknométerek Fecskendők Kémcsövek, egyéb csövek Egyéb üvegáruMűanyag eszközök
Tárolóedények Mérőeszközök Főzőpoharak, lombikok, edények Spriccflakonok, cseppentőflakonok, permetezők Csövek, tesztcsövek Pipettahegyek Állványok, tárolódobozok, tálcák Teflonszerű műanyagból készült termékek Sejttenyésztéshez és mikrobiológiához használt eszközök Kanalak, spatulák, csipeszek Tölcsérek Egyéb műanyag eszközök
-
-
Készülékek, műszerek
-
- Kromatográfiás termékek
- Védőfelszerelések
-
Gyorstesztek
-
Chromogenic Compact Dry™ táptalajok
Ár kérése
A kromogén táptalajok a mikrobiológiában használt speciális táptalajok, amelyek a mikroorganizmusok azonosítására szolgálnak a képződött telepek színe alapján. A szín a táptalajban lévő anyagokból származik, amelyek kölcsönhatásba lépnek az azonosítandó mikroorganizmus(ok) specifikus anyagcsereútjaival.
A CompactDry egy használatra kész módszer, amely csökkenti a mikrobiális elemzési időt és javítja a minőségellenőrzési folyamatokat. A CompactDry® dehidratált, szelektív és kromogén táptalajok az össz-mikrobiális szám és/vagy a mikrobiális fajok azonosítására. Alkalmazási területei a nyersanyagok, élelmiszerek, italok, kozmetikumok szabályozása, valamint a környezeti levegő és/vagy felületek monitorozása.
| Típus | Leírás |
|---|---|
| Compact Dry® AQ | A lemez tápanyagban szegény táptalajt tartalmaz a heterotróf organizmusok telepszámának meghatározására kezelt ivóvízben és ultratiszta vízben. |
| Compact Dry® CF (Coliforms) | Koliformok kimutatására szolgáló táptalaj |
| CompactDry™ EC (E. coli and coliforms) | A CompactDry™ EC egy táptalaj az E. coli és a coliform baktériumok kimutatására. A táptalaj két különböző kromogén enzim szubsztrátot tartalmaz: Magenta-Gal és X-Gluc. |
| CompactDry™ ETB for Enterobacteriacae | A CompactDry™ ETB egy nagyon könnyen használható rendszer az Enterobacteriacae kimutatására. Szubsztrátjai lehetővé teszik az Enterobacteriacae megkülönböztetését más csoportoktól. |
| Compact Dry® ETC (Enterococos) | Kromogén táptalaj az Enterococos kimutatására. |
| CompactDry™ LS for Listeria species | A CompactDry™ LS-t a Listeria mennyiségi kimutatására használják élelmiszerekben és italokban. Felületek és munkakörnyezetek értékelése a CompactDry™ mintavevő segítségével. |
| CompactDry™ PA for Pseudomonas aeruginosa | CompactDry™ PA a Pseudomonas aeruginosa mennyiségi kimutatására. |
| Compact Dry® SL (Salmonella) | Salmonella kimutatási táptalaj, 20-24 órával a dúsítás előtt, elődúsítási táptalajokban. |
| CompactDry™ TC (Total Count) | A CompactDry™ TC egy táptalaj az összes életképes baktériumszám meghatározásához, amely tápanyag-standard agart tartalmaz. |
| Compact Dry® VP (Vibrio parahaemolyticus) | V. parahaemolyticus kimutatási táptalaj, amely lehetővé teszi a megkülönböztetését más vibrióktól, a szervezet számára kromogén szubsztrát jelenlétének köszönhetően. |
| Compact Dry® X-BC (Bacillus cereus) | Bacillus cereus kimutatási táptalaj. |
| CompactDry™ X-SA for Staphylococcus aureus | A CompactDry™ X-SA egy táptalaj, amelyet a Staphylococcus aureus szelektív növekedés és differenciálás útján történő meghatározására használnak. |
| CompactDry™ YM for yeast and mould | A CompactDry™ YM a jellegzetes színfejlődés és morfológia alapján különbözteti meg az élesztő- és penészgombákat. A CompactDry™ YM nagyon jó 3 dimenziós növekedést tesz lehetővé az élesztő- és penészgombák számára. |
| Compact Dry® YMR rapid (moulds and yeasts) | Penész- és élesztőgombák kimutatására szolgáló közeg |
Ajánlatkérés
Kapcsolódó termékek
2026 | Design és fejlesztés: Make It Online
 Belépés / Regisztráció
Belépés / Regisztráció